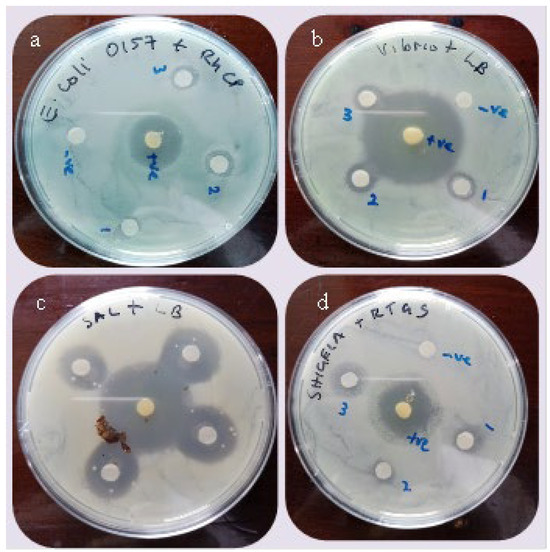

Abstract
Constructed wetlands are increasingly recognised for their potential in wastewater treatment, particularly in the removal of pathogenic microorganisms. However, the mechanisms of removal are not fully understood. This study investigated the role of endophytic and rhizosphere fungi and associated secondary metabolites in the removal of pathogenic bacteria from wastewater. Endophytic and rhizosphere fungi were isolated from roots of wetland macrophytes (T. latifolia, C. papyrus and P. mauritianus) and screened for their antimicrobial effects on E. coli, Shigella spp., Salmonella spp. and Vibrio spp. Secondary metabolites were extracted from fungal isolates (broth cultures) and tested for their antibacterial activity as a possible mechanism of pathogen removal. Antimicrobial activity of the fungi and their metabolites, measured as zones of inhibition, was analysed using ANOVA at a 5% significance level. Active secondary metabolites were identified using GC-MS techniques. Four fungal isolates (three endophytic, one rhizospheric) from the genus Candida exhibited antimicrobial activity against E. coli, Salmonella spp., Shigella spp. and Vibrio spp. in vitro. There were significant differences in inhibition zones (p < 0.0001) between the different species of fungi. Fungus RTGRS did not show any antibacterial activity on Vibrio spp. and Shigella spp. but showed the highest zones of inhibition of 21.17 ± 0.75 against Salmonella spp. This study demonstrated that the selected wetland macrophytes harbour both endophytic and rhizosphere fungi that can produce bioactive compounds that have antimicrobial properties, inhibiting the growth of pathogenic bacteria E. coli, Salmonella spp., Shigella spp. and Vibrio spp., contributing to pathogen removal in CWs. The findings have implications for the design and operation of CWs, as it is important to select macrophytes that harbour fungi with antimicrobial properties. More research is needed on the use of these fungi in wastewater treatment in full-scale CWs.
1. Background
The rapid population growth, which is expected to reach 9.9 billion in 2050 [1], and economic growth have placed pressure on freshwater resources, with many regions facing water crisis [2,3,4,5,6], especially in urban areas. In addition, increased per-capita water use, over-abstraction of groundwater, climate change and extended contamination of water sources have resulted in water scarcity [6,7]. Hussain et al. [5] report that one billion people are without adequate fresh and drinking water, and it is projected that the number will increase to 1.8 billion by the year 2025 [4]. A recent report by Garatsa et al. [7] estimated that 1.42 billion people, including 450 million children, live in areas with water scarcity of different extremes, and 3.6 billion people lack safely managed sanitation services.
In the last decade, there has been a growing interest in the reclamation and reuse of wastewater to supplement water resources in Zimbabwe [8,9,10]. Nonetheless, treating wastewater presents significant challenges in low- to middle-income countries [11]. In most cases, installed wastewater treatment systems fail to cope with the large volumes of wastewater discharge [3,11] and sufficiently reduce pollutant concentrations to levels acceptable for reuse and discharge into the environment. The last decades have recorded significant increases in the presence of both pathogenic and non-pathogenic microorganisms in municipal and domestic wastewater [12], threatening wastewater reuse [13]. The presence of pathogenic microorganisms (bacteria, viruses, protozoa, fungi) in wastewater has been implicated in the outbreaks of gastrointestinal tract diseases in Zimbabwe, including typhoid fever [14], cholera [15] and amoebic dysentery [16]. The common enteropathogenic microorganisms found in wastewater include enterococci, Escherichia coli, Bacillus spp., Streptococcus pyogenes, Citrobacter spp., Klebsiella pneumonia, Klebsiella aerogenes [17], Pseudomonas aeruginosa, Staphylococcus aureus and Salmonella enterica [18]. These pathogens can lead to diseases such as diarrhoea, typhoid, paratyphoid fever, cholera, infectious hepatitis, giardiasis and amoebic/bacillary dysentery, all of which affect the gastrointestinal tract [12,19]. Removal of the pathogens from wastewater is a critical intervention to limit incidences of gastrointestinal diseases and contamination of freshwater sources, as evidenced by Norman et al. [20].
The increasing demand for low-cost and environmentally sustainable wastewater solutions has led to the exploration of biological treatment methods, such as phytoremediation using constructed wetlands (CWs). Constructed wetlands offer nature-based technology that uses the ecosystem services of wetland macrophytes, soils and their microbial communities to remove contaminants from wastewater [2,21]. The use of CWs evolved during the second half of the twentieth century, with pioneering work in Germany [22], particularly by Käthe Seidel in the early 1950s [23]. The research and technology subsequently spread to other countries only in the 1990s and 2000s [24]. Since then, several studies have been undertaken on the effectiveness of different CW designs in the treatment of various types of wastewater, including domestic, municipal, mining, and industrial wastewater, as well as agricultural effluents [6,25,26]. Furthermore, the technology has proved effective and has been widely applied in many countries, including the United Kingdom, Austria, Slovenia, Switzerland and Denmark [22].
Constructed wetland systems can efficiently reduce, remove, degrade or immobilise pollutants from a wide range of residential, industrial and agricultural wastewater [2]. Within CW beds, macrophytes have specific critical roles that provide overall bioremediation support, and these are based on their unique properties [2,27]. Studies have reported that within the rhizosphere, chemical, biological and physical interactions occur, resulting in the removal of pollutants from wastewater [28,29].
Several macrophytes, including Typha latifolia and Typha dominguensis [30,31,32], Phragmites australis [33], Cyperus papyrus [34] and Echinochloa pyramidalis [35], have been tested and shown to be efficient in reducing pathogen loads of wastewaters. However, it is not yet fully understood how the macrophytes remove pathogens from wastewater. Some plants have shown the ability to internalise microorganisms, including bacteria [11,36,37,38] and viruses [37]. In addition, roots of certain plants produce secondary metabolites or exudates that play a significant role in regulating plant–plant and plant–microbial interactions [39]. These substances, particularly those with antimicrobial characteristics, may play a significant role in the elimination of harmful microorganisms from wastewater.
Recent studies have highlighted the potential of fungi, particularly endophytic and rhizosphere fungi, to contribute to the remediation of wastewater in CWs. Endophytic fungi are found in plants and help the host plant cope with biotic and abiotic stressors [40]. It is known that these microbes live inside plant tissues without seeming to affect the host [41]. The fungal endophytes reportedly produce a vast range of secondary metabolites, with many compounds having antibacterial activity [41,42,43]. For instance, Sundar and Arunachalam [44] isolated secondary metabolites from the endophytic Fusarium oxysporum TPL11 fungus of the Tradescantia pallida plant. Among the metabolites produced was the phenolic compound, 2,4-di-tert-butylphenol (DTB), which exhibited antagonism against human pathogens [44]. These results support earlier findings by Juan et al. [45], which revealed that endophytic fungi isolates from Dendrobium devonianum and D. thyrsiflorum exhibited antimicrobial activity against at least one pathogenic bacterium or fungus. This has sparked the interest of numerous researchers, though much of the focus has been on exploring the diversity of fungi associated with medicinal plants and investigating the bioactivity of the secondary metabolites they produce [3,41,46]. Alkaloids, steroids, terpenoids, flavonoids, glycosides, xanthones, isocoumarins, quinones, phenyl propanoids, lignans, aliphatic metabolites, and lactones are among the secondary metabolites of fungal metabolism that are commonly isolated in plants that harbour these fungi [47]. These findings reinforced the assumption that endophytic and rhizosphere fungi could play a potential antibacterial role in the treatment of wastewater in CWs.
Endophytic and rhizosphere fungi have not received enough attention as a source of bioactive and chemically unique substances involved in the elimination of microorganisms during wastewater treatment in CWs. The various bioactive compounds produced by these microorganisms can be instrumental in the disinfection or inactivation of pathogenic bacteria, both those in the rhizosphere and those internalised within plant tissues. This offers an enormous potential for exploitation in the destruction of pathogenic microorganisms in wastewater during treatment in CWs. We therefore hypothesise that wetland macrophytes host fungi (both endophytic and in the rhizosphere) that produce compounds with antimicrobial activity against human enteric bacteria. It is against this background that this study isolated endophytic and rhizosphere fungi from the selected wetland macrophytes T. latifolia, P. mauritianus and C. papyrus, and explored their antimicrobial activities against a number of human pathogens present in wastewater. The specific objective was to determine the key secondary metabolites produced by rhizospheric and endophytic fungi of the selected macrophytes (T. latifolia, P. mauritianus and C. papyrus) and their antimicrobial activities on enteropathogens (Escherichia coli O157: H7, Shigella spp., Vibrio spp. and Salmonella spp.).
2. Materials and Methods
2.1. Study Area
The study was conducted in Bindura (17°30′18″ S and 31°19′49″ E), a town that is 90 km north-east of the capital city of Zimbabwe, Harare (Figure 1). The study area encompasses various sites within Bindura, including the sampling site indicated on the map (Figure 1) and Bindura University of Science Education, Astra campus, where laboratory experiments and analyses were conducted. Bindura is characterised by hot, dry and wet summers (September–March) and cold, dry winters (May–August). The town receives an average annual rainfall of 810 mm, and the mean daily temperature range is 12–26 °C.

Figure 1.
Map of study area.
2.2. Endophytic and Rhizosphere Fungi in Macrophytes T. latifolia, C. papyrus and P. mauritianus and Their Antimicrobial Activity
The study investigated the antimicrobial activity of metabolites produced by fungal endophytes on pathogenic bacteria. Figure 2 outlines the culture-dependent study design, and the detailed description of the methods is given under the subsections that follow.

Figure 2.
Summary of stages from isolation of endophytic fungi to identification of metabolites.
2.2.1. Collection of Wetland Macrophytes
Twenty fresh and healthy macrophytes each of T. latifolia, P. mauritianus and C. papyrus were randomly selected from three sampling sites (see Figure 1) within a heavily polluted natural wetland receiving effluent from the Trojan mine wastewater treatment plant in Bindura. For each plant species, the samples were immediately sectioned using sterile blades into roots, stems and leaves. The tissues were combined and placed separately into sterile plastic bags. The samples were subsequently taken to the laboratory in a cooler box for isolation of endophytic and rhizosphere fungi.
2.2.2. Isolation of Endophytic and Rhizosphere Fungi
The study applied a culture-dependent method to isolate endophytic fungi from wetland macrophytes according to dos Reis et al. [48]. While some fungi are challenging to grow under laboratory conditions [49] and difficult to identify using morphological characteristics [50], the culture-based methods were still used to explore the potential ability of antimicrobial fungi to inhibit the growth of pathogenic bacteria.
Endophytic fungi were isolated from plants according to a protocol by Jayatilake and Munasinghe [40] with some modifications. Plant samples collected as described in Section 2.2.1 were gently washed with running tap water to dislodge any soil particles adhering to the tissues. Composite samples of root, stem and leaf sections from the different plants were sliced into small pieces measuring 3–4 cm and mixed. The plant pieces were then surface sterilised by immersing them in 5% NaOCl solution for 3 min before being washed twice in sterile distilled water (SDW) to eliminate epiphytic bacteria. The samples were then submerged in 70% ethanol for 1 min before being washed three times in sterile distilled water. To confirm surface disinfection efficiency, sterile samples were placed on fresh Potato Dextrose Agar (PDA) and left for 30 min to obtain imprints. After removing the fragments, the agar plates were incubated at 28 ± 2 °C for 3–5 days.
The surface-sterilised plant tissues were then sectioned and fragmented under aseptic conditions. Specifically, rhizomes and roots of T. latifolia were longitudinally and cross-sectioned using sterile blades and placed on PDA. Roots for C. papyrus and P. mauritianus were crushed in a sterile mortar, and sample tissue was placed on PDA. Although several culture media are available for isolating endophytic fungi, PDA has been used in this study since it is the most often used and supports a wide range of fungal species [48]. Plates were incubated for 4–6 days at 28 ± 2 °C. To purify the fungal culture, hyphae developing along colony boundaries were carefully selected and transferred to a new, sterile media plate. This procedure was conducted multiple times until a single, homogeneous strain of endophytic fungus, with constant colony appearance, was isolated.
2.2.3. Isolation of Fungi from Macrophyte Rhizosphere
Healthy macrophytes of T. latifolia, P. mauritianus and C. papyrus were uprooted together with the soil and placed in sterile polythene bags. Fungi were isolated in the laboratory using modified procedures developed by Jayatilake and Munasinghe [40] and Marcellano et al. [46]. The soil particles attached to the roots were carefully scraped with sterile scalpel blades and weighed under aseptic conditions. For each gram of soil added to an Erlenmeyer flask, 10 mL of sterile distilled water was added, and the mixture was blended by shaking the flask at 150 rpm with a shaker for 5 min. The mixture was allowed to set, and the supernatant produced was serially diluted (10-fold dilutions up to 10−5). For each dilution, 100 μL of sample was plated on PDA agar in triplicate. The plates were sealed with parafilm to prevent contamination and drying of the culture medium [48]. They were then incubated at 28 ± 2 °C for 4–6 days. The growing fungal colonies were subcultured onto fresh PDA at an incubation temperature of 28 ± 2 °C for 5 days. Repeated subculturing of the colonies on PDA plates produced pure cultures of the rhizosphere fungi. The isolated pure cultures were stored in inclined cryotubes at 4 °C according to a modified method by Wang et al. [50]. Briefly, mycelia were transferred to 20% glycerol in ultrapure distilled water and stored at 4 °C.
Preliminary identification of fungi was performed at the Biology Laboratory at Bindura University of Science Education (BUSE), by means of analysis of morphological and microscopic characteristics of colonies. Only fungi that showed antimicrobial activity were subjected to further biochemical identification in the Mycology Laboratory, Faculty of Medicine and Health Sciences, University of Zimbabwe. The API 20C biochemical identification system was used to identify the fungal isolates.
2.2.4. Preliminary Screening of Endophytic and Rhizosphere Fungi for Antimicrobial Activity
The antibiotic activity of all isolated endophytic and rhizosphere fungi was tested using the agar plug diffusion assay method published by Marcellano et al. [46], with some modifications. Endophytic and rhizosphere fungi were grown in SDA for 5 days at 28 ± 2 °C. Lawns of test bacteria (Salmonella spp., Shigella spp., Vibrio spp. and E. coli) were prepared by inoculating and spreading in Petri dishes with Mueller–Hinton Agar (MHA) using a sterile cotton swab. Mueller–Hinton Agar was used in this study because it has good reproducibility, low in sulfonamide, trimethoprim and tetracycline inhibitors, and gives satisfactory growth of most bacterial pathogens [51]. A 6 mm cork-borer was then used to cut six-millimetre-diameter agar plugs from the SDA plate of actively developing endophytic and rhizosphere fungi. After being seeded with the test bacteria, the agar plugs were moved to the MHA. To allow metabolites to disperse, the plates were wrapped in parafilm and refrigerated at 4 °C for 12 h. The plates were then incubated in triplicate at 37 °C for a full day. A ruler was used to measure the average diameter of the zones of inhibition (ZOI) after a 24 h incubation period.
2.3. Antimicrobial Activity of Endophytic and Rhizosphere Fungi Extracts
2.3.1. Preparation of Ethyl Acetate Extracts by Fermentation of Endophytic and Rhizosphere Fungi
Following modified procedures by Jayatilake and Munasinghe [40] and Marcellano et al. [46], secondary metabolites were isolated from fungi that demonstrated antibacterial activity in the initial screening phase. A sterile cork-borer was used to remove three agar plugs (6 mm diameter) from pure cultures of endophytic and rhizosphere fungi that were actively developing. For each fungal isolate, three agar plugs were added to 100 mL of Potato Dextrose Broth (PDB). The mixtures were incubated at 28 ± 2 °C on a shaker at 150 rpm for two weeks. After the two-week incubation phase, a double-layered muslin cloth was used to filter the broth culture to extract the filtrate from the mycelia mat. To ensure complete removal of the mycelia, centrifugation of the filtrate was carried out at 4000 rpm for 15 min. The supernatant was then mixed with 150 mL of ethyl acetate in a separating funnel, with gentle agitation. The mixture was left to stand for an hour to settle out. The mixture formed two layers, and the ethyl acetate was separated from the mycelium-free culture. The separation process was repeated three times. The ethyl acetate extracts were pooled and dried in a rotary evaporator (150 rpm at 38 °C).
2.3.2. Antimicrobial Activity of Fungal Crude Extracts
Using the disc diffusion method as outlined by Marcellano et al. [46], the antibacterial activity of the crude ethyl acetate extracts was evaluated. The disc diffusion method has been used in this study because of its relative simplicity and ability to easily test multiple antimicrobial agents on each bacterial isolate [52]. Twenty-four-hour-old cultures were used to create test bacterial suspensions. Based on the 0.5 McFarland Standard, the concentrations of bacterial suspensions were standardised to contain roughly 1.5 × 108 CFU/mL cells. Then, 100 µL of each standardised bacterial suspension (E. coli O157: H7, Salmonella spp., Shigella spp. and Vibrio spp.) was spread on Mueller–Hinton Agar (MHA). An inoculum was prepared by dissolving dried crude ethyl acetate extract in 0.1% dimethyl sulfoxide (DMSO) to achieve a 100 mg/mL concentration. After that, sterile circular discs (produced from Whatman Paper No. 1 filter paper), with a diameter of 5 mm, were eluted with 30 µL of the dissolved extract and left to dry for an hour. For each extract, four paper discs were placed and positioned at an equal distance apart on the bacteria-inoculated MHA agar plates. Additionally, gentamicin discs and paper discs eluted with 30 µL of 0.1% DMSO were added to the MHA plate as positive and negative controls, respectively. The plates were sealed with parafilm and incubated for 24 h at a temperature of 37 °C. The zones of inhibition that established during incubation were measured using a ruler.
2.3.3. Identification of Secondary Metabolites Produced by Endophytic Fungi
Identification of compounds in ethyl acetate extracts was carried out at Government Analyst Laboratories, Harare, Zimbabwe, using Agilent Gas Chromatography–Mass Spectrometry (GC-MS) Agilent Technologies International, New Delhi, India. Twenty millilitres of broth was extracted with 10 mL of ethyl acetate in a separating flask. After extraction, the ethyl acetate was evaporated on a water bath to dryness. The sample was then reconstituted into 10 mL of HPLC methanol. The extract was filtered with a 0.4 µm filter into a vial. The chemical compounds in the crude extracts from the isolates were then determined using the Agilent GC-MS. The analysis utilised 5% Diphenyl/95% Dimethyl polysiloxane column, and Helium gas (99.99%) as a carrier gas. Injector and ion-source temperatures were set at 250 °C and 230 °C, respectively. The oven operating temperatures were as follows: 100 °C (held constant for 2 min) followed by an increment of 10 °C/min to 300 °C, which was held constant for 10 min. Mass spectra were taken at 70 eV at 2.5 scans per second. Compound identification was based on peak measurement and the retention time, and was matched against the NIST 14 database.
2.3.4. Data Analysis
To summarise and understand the central tendency and variability in the antibacterial activity of secondary metabolites produced by isolated fungi, descriptive statistics were used. For each fungus and metabolite combination, the mean, standard deviation and range of zone of inhibition were determined using R software version 4.1.3. Box plots were created for visual comparison of zones of inhibition across different bacterial species and secondary metabolites. Analysis of Variance (ANOVA) at a 5% significance level was used to determine if there were statistically significant differences in the zones of inhibition among the different secondary metabolites and bacterial species. In cases where ANOVA tests indicated significant differences, post-hoc testing (the Bonferroni correction) was performed to identify specific group differences.
3. Results
3.1. Antimicrobial Activity of Endophytic and Rhizosphere Fungi Agar Plug Tests
A total of eleven fungi isolates were recovered from surface-sterilised roots and rhizomes of wetland macrophytes T. latifolia, C. papyrus and P. mauritianus. Of these, nine were consistently found in all plant samples. Four isolates, code-named RTGS, RTGRS, LB and RHCP, demonstrated antibacterial activity by inhibiting the growth of at least one of the test bacteria, E. coli, Salmonella spp. and Vibrio spp., as shown in Figure 3. The endophytic and rhizosphere fungi were identified morphologically and biochemically as all yeasts from the genus Candida. The API 20C identification method successfully identified the isolate RTGS as Candida kefyr in 48 h. However, the method could not identify the other three isolates (RTGRS, LB and RHCP) to the species level. Of these three, RHCP was isolated only from the C. papyrus rhizosphere.
Figure 3.
Zones of inhibition produced by crude secondary metabolites extracted from broth cultures of endophytes (a) RHCP on E. coli O157: H7 (b), LB on Vibrio spp. (c), LB on Salmonella spp. (d) RTGS on Shigella spp. Fungi names are code names.
3.2. Antimicrobial Activity of Secondary Metabolites of Endophytic and Rhizospheric Fungi
In this study, secondary metabolites were extracted from broth cultures of the rhizosphere and endophytic fungi and their antimicrobial activity was assessed against enteropathogens (E. coli, Shigella spp., Salmonella spp. and Vibrio spp.) as a potential mechanism of pathogen removal in constructed wetlands. To summarise and understand the central tendency and variability in the antibacterial activity of secondary metabolites produced by isolated fungi, descriptive statistics were used. ANOVA tests were used to assess the antibacterial activity of secondary metabolites against selected enteropathogenic bacteria.
The antimicrobial activity of ethyl acetate crude extracts from Sarbaroud Dextrose broth cultures of endophytic and rhizospheric fungi was examined in vitro using the disc (5 mm) diffusion method, resulting in the zones of inhibition illustrated in Figure 3.
Table 1 and Figure 4 show the mean zones of inhibition for crude secondary metabolites produced by four fungal species.

Table 1.
Summary statistics for the zone of inhibition for secondary metabolites from fungal species within each bacterium.

Figure 4.
Mean inhibition zone of secondary metabolites from fungal broth cultures against bacterial species (1: E. coli, 2: Shigella spp., 3: Salmonella spp., 4: Vibrio spp.); fungal species (1: RTGS, 2: RTGRS, 3: LB, 4:RHCP).
Table 2 shows the results of the analysis of variance (ANOVA) test for the effects of secondary metabolites produced by fungi (RTGS, RTGRS, LB and RHCP) on bacterial species (E. coli, Shigella spp., Salmonella spp., and Vibrio spp.).

Table 2.
ANOVA results showing test statistics for the effects of fungal species (fungi RTGS, RTGRS, LB and RHCP), bacteria (E. coli, Shigella spp., Salmonella spp. and Vibrio spp.) and their interaction on the inhibition zone test.
The p-value for fungal species is <0.0001, suggesting that there are significant differences in inhibition zones between the different species of fungi. This means that at least one fungal type is significantly more or less effective in inhibiting bacterial growth compared to others. The p-value for bacterial species is <0.0001, which is also significant. This indicates that there are significant differences in inhibition zones across bacterial species, suggesting that certain bacterial types are susceptible to secondary metabolites produced by fungi. The interaction between the fungal secondary metabolites and the bacterial species was also tested and showed a p-value of <0.0001. This significant interaction suggests that the efficiency of fungal species in preventing bacterial growth differs according to the type of bacterium. This means that some fungi are more effective against specific bacteria than others. Thus, pairwise comparisons between species of fungi within each bacterial species were performed to identify specifically which fungal metabolite was the most effective for each bacteria type.
Pairwise comparisons between species of fungi within the E. coli bacteria produced p-values ≥ 0.05, signifying that there is no single fungal species that is more effective against E. coli than others. Pairwise comparisons between species of fungi within the Shigella spp. produced p-values that are significant. The p-values for the species RTGS–RTGRS (<0.0001), RTGRS–LB (<0.0001), RTGRS–RHCP (<0.0001) and LB–RHCP (0.0021) are significant. The significant contrasts between fungal species RTGRS and LB and between LB and RHCP confirm that species LB’s inhibition zone (11.83) is significantly higher than the other fungal species, reinforcing its status as more effective than RTGRS and RHCP. There was no significant contrast reported between species RTGS and LB, which means that they could be statistically similar. However, the mean inhibition zone for species LB is higher than RTGS (11.83 vs. 10.33); thus, fungal species LB remains the most effective species in inhibiting Shigella spp.
Pairwise comparison results for Salmonella spp. produced significant p-values except for the contrast between fungal species RTGS and RHCP. Given the estimated mean inhibition zones for the four fungi types against Salmonella spp. bacteria, fungal species RTGRS has the highest mean inhibition zone (21.17), indicating it is potentially the most effective against Salmonella spp. Examining the significant pairwise comparisons, fungal species RTGRS shows significant contrasts with RTGS, LB and RHCP, confirming that its inhibition zone is significantly higher than all others and that it is the most effective in inhibiting the growth of Salmonella spp.
Pairwise comparison between fungal species for Vibrio spp. produced significant p-values except for the contrast between fungal species RTGS and RHCP. After examining the significant pairwise comparisons, fungal species RTGS has significant contrasts with RTGRS and LB. This indicates that species RTGS is significantly more effective than both RTGRS and LB. In addition, fungal species RHCP also shows significant contrasts with RTGRS and LB, but is not significantly different from RTGS. Since fungal species RTGS and RHCP have very similar inhibition zones (19 and 18.83) and do not differ significantly from each other, they can be considered equally effective. Therefore, we can conclude that fungal species RTGS and RHCP are the most effective in killing Vibrio spp.
3.3. Identification of Secondary Metabolites Produced by Endophytic and Rhizosphere Fungi
The secondary metabolites in crude ethyl acetate extracts from the four Candida species (RTGS, RTGRS, LB and RHCP) isolated from wetland macrophytes were identified and quantified using gas chromatography–mass spectrometry (GC-MS) analysis. The analysis of the extracts identified a wide range of compounds, totalling 21, as shown in Table 3.

Table 3.
Compounds identified in crude ethyl acetate extracts of four Candida species isolated from wetland macrophytes by GC–MS analysis and mass spectra of NIST database.
The analysis of ethyl acetate crude extracts of LB revealed the highest number of compounds (17 of the 21), including those that were not detected in extracts of RTGS, RHCP and TRGRS. Extracts of RTGS, RHCP and RTGRS revealed eight, eight and seven compounds, respectively.
GC-MS analysis of the crude extracts revealed only six compounds that were present in all four extracts, namely Undecane, Dodecane, Cyclohexasiloxane, dodecamethyl, 2,4-Di-tert-butylphenol, Hexadecane and Pyrrolo[1,2-a]pyrazine-1,4-dione, hexahydro-3- (2-methylpropyl). Among these compounds, Decane, 2,4-Di-tert-butylphenol and Pyrrolo[1,2-a]pyrazine-1,4-dione, hexahydro-3- (2-methylpropyl) were the most abundant. The compound Hexadecanoic acid, methyl ester, was detected only in extracts of RTGS, whereas 2,5-Hexanediol, 2,5-dimethyl was present only in extracts of RHCP. Figure 5 displays the chemical structures of major and common compounds detected in the crude extracts.

Figure 5.
Chemical structures of major secondary metabolites detected in ethyl acetate extracts: (a) Benzene, 1,3-bis(1,1-dimethylethyl), (b) Cyclohexasiloxane, dodecamethyl, (c) 2,4-Di-tert-butylphenol, (d) Pyrrolo[1,2-a]pyrazine-1,4-dione, hexahydro-3- (2-methylpropyl).
4. Discussion of Results
This work evaluated the possible contribution of rhizosphere and endophytic fungi, as well as related secondary metabolites, on the elimination of enteropathogens from wastewater in CWs. According to the study, endophytic and rhizosphere fungi isolated from the wetland plants T. latifolia, C. papyrus, and P. mauritianus have antibacterial properties against human enteropathogens and may be used to remediate wastewater. The observed antimicrobial activity of fungal agar plugs and crude extracts from the isolated fungi against human enteropathogenic bacteria (E. coli, Salmonella spp., Shigella spp. and Vibrio spp.) suggests that they could play a crucial role in the biological treatment process in CWs. The antimicrobial activity shown by the fungi is attributed to the several bioactive metabolites they produce. Previous studies have extracted secondary metabolites belonging to terpenoids, phenolics, alkaloids and flavonoids, which exhibited antimicrobial properties [40]. The production and release of these and other associated compounds in CWs was therefore thought to contribute to the observed pathogen removal.
Numerous studies have investigated the antimicrobial properties of fungal crude extracts against pathogenic bacteria, demonstrating varying levels of effectiveness as antimicrobial agents [40,53,54,55]. The antibacterial action of fungi that have been isolated from wetland plants, however, is not well understood. In the current study, crude extracts produced by endophytic and rhizosphere yeasts from the genus Candida were shown to have significant antimicrobial activities against E. coli, Salmonella spp., Shigella spp. and Vibrio spp. The effectiveness, however, varied with some fungal extracts showing high antimicrobial activity against specific bacteria. The extract’s antibacterial potency or the high concentrations of unknown bioactive compounds in the extracts are the two possible explanations for the variations in efficacy for each fungus [55].
Endophytic and rhizosphere fungi have been isolated from various plant species and tested for antimicrobial activity. Many fungal isolates demonstrated antimicrobial activity, for example, Penicillium commune and Penicillium canescens [56], Fusarium spp. [41], Aspergillus cejpii [57], Trichoderma virens and Trichoderma asperellum [40] and Cochlibolus affinis and Penicillium guepinii [58]. Of the four endophytes that showed antimicrobial activity in this study, Candida kefyr was the only fungi isolated from both roots and rhizomes of C. papyrus. Although crude extracts from Candida kefyr had antimicrobial activity against all bacteria, their highest activity was against Vibrio spp. The presence of such fungi in the rhizosphere revealed a symbiotic relationship with plants that is essential for the eradication of pathogenic bacteria within the rhizosphere. Understanding the plant–fungus and fungus–bacteria interactions in CWs is therefore critical as they contribute to pathogen removal. Furthermore, the antimicrobial activity demonstrated by endophytic fungi is an indication that the macrophytes can eliminate the internalised bacteria within the tissues, reducing the chances of reintroduction into the water column. The antibacterial activity demonstrated by the rhizosphere fungi suggests that the secondary metabolites produced can inhibit the growth and multiplication of bacteria in wastewater.
A study by Malhadas et al. [56] observed that the incorporation of plant host extract in culture media enhances the ability to induce or repress the antimicrobial activity of fungal extracts. This suggests that the observed activity may be improved with the addition of plant host extracts. However, within CWs, the fungus will be associated with the plant; thus, it is expected that higher activity will be achieved. However, endophytes may either stop producing bioactive material after a given amount of time or continue to do so [59]. To maximise the effectiveness of engineered wetland designs against pathogenic bacteria, additional research is therefore required to investigate the factors that encourage the formation of antimicrobial metabolites, both in vitro and in situ.
The GC-MS findings from the study show that endophytic and rhizosphere fungi can produce a range of secondary metabolites, some of which are thought to have antibacterial qualities. Candida species have been isolated from a selection of wetland macrophytes, and the detection of compounds from ethyl acetate extracts from these isolates suggests that the yeasts are capable of removing bacteria, both from within the plant and in the rhizosphere. The GC-MS analysis results of this study have revealed secondary metabolites, which are consistent with those reported in other studies. Interestingly, several of the identified compounds have been previously documented to display antibacterial properties. For example, 2,4-Di-tert-butylphenol (2,4-DTBP), Pyrrolo[1,2-a]pyrazine-1,4-dione, hexahydro-3- (2-methylpropyl), Hexadecanamide, Benzene, 1,3-bis(1,1-dimethylethyl) and Hexadecane have been shown to possess antibacterial activity [60].
The endophytic and rhizosphere fungi’s crude extracts include 2,4-DTBP, which implies that these substances may be utilised to regulate bacterial growth in wetland environments. The lipophilic phenol 2,4-DTBP was reported in at least 169 species of organisms and exhibits potent toxicity against several organisms [61]. Seenivasan et al. [62] evaluated the bioactivity of ethyl acetate crude extracts obtained through the fermentation of endophytic Streptomyces species KCA1 isolated from Phyllanthus niruri leaves. The crude extracts demonstrated broad-spectrum efficacy against different microorganisms. Following further purification and investigation, the active metabolite was discovered as 2,4-Di-tert-butylphenol. The compound was capable of inhibiting the growth of E. coli ATCC 25922 and S. aureus ATCC. Furthermore, a study by Rouvier et al. [63] in Rwanda also demonstrated antimicrobial activity of 2,4- DTBP obtained from propolis OFAP18 by the inhibition of C. acnes growth. Besides inhibiting growth, bactericidal assay with 2,4-DBP exhibited synergism with ampicillin to kill Pseudomonas aeruginosa [64].
The compound Pyrrolo[1,2-a]pyrazine-1,4-dione, hexahydro-3-(2-methylpropyl) has been reported for its antibacterial activity in several studies [53,65]. Kumari and Menghani [53] investigated and reported antibacterial activity of ethyl acetate extracts isolated from rhizospheres of Actinomyces. Further analysis revealed that compounds Pyrrolo[1,2-a]pyrazine-1,4-dione, hexahydro-3-(2-methylpropyl) and Pyrrolo[1,2-a]pyrazine-1,4-dione, hexahydro-3-(phenylmethyl) were responsible for the antimicrobial activity of the extracts. This observation is in line with findings by Putra and Karim [65], which showed antibacterial activity of Pyrrolo[1,2-a]pyrazine-1,4-dione, hexahydro-3-(2-methylpropyl) and Pyrrolo[1,2-a]pyrazine-1,4-dione, hexahydro-3-(phenylmethyl) against Gram-negative bacteria (Escherichia coli ATCC 25922, Vibrio cholerae ATCC 14035). However, these results may not be compared to our findings, as they used pure extracts, which produced relatively large zones of inhibition, ranging from 16 to 26 mm against human pathogens [44].
These and other metabolites produced by endophytic and rhizosphere fungi employ several mechanisms to inhibit the growth of microorganisms. For example, 2,4-DTBP and Pyrrolo[1,2-a]pyrazine-1,4-dione, hexahydro-3-(2-methylpropyl) and Pyrrolo[1,2-a]pyrazine-1,4-dione, hexahydro-3-(phenylmethyl), have been reported to inhibit quorum sensing, a mechanism which regulates bacterial physiological activities, including virulence, parthenogenesis, biofilm formation, swimming and swarming motility [64,66]. Furthermore, 2,4-DTBP interferes with exopolysaccharide secretion, energy production, membrane transport, membrane permeability, reactive oxygen (ROS) production and electrolyte leakage [67]. These mechanisms can lead to cell death, reducing microbial populations and the risk of waterborne diseases.
5. Conclusions and Recommendations
This study demonstrated that wetland macrophytes harbour both endophytic and rhizosphere fungi that can produce bioactive compounds that have antimicrobial properties, inhibiting the growth of pathogenic bacteria E. coli, Salmonella spp., Shigella spp. and Vibrio spp. The antimicrobial activity demonstrated in this study suggests that endophytic and rhizosphere fungi can contribute to pathogen removal in CWs. The findings have implications for the design and operation of CWs, as it is important to select macrophytes that harbour fungi with antimicrobial properties. More research is needed on the use of these fungi in wastewater treatment in full-scale CWs.
The study demonstrated that endophytic fungi and associated secondary metabolites inhibit the growth of bacteria. Although the in vitro results are promising, they may not fully reflect real-world performance in CWs. Further studies in situ or in microcosms will go a long way to unpacking the role of endophytic and rhizosphere fungi in wastewater treatment in CWs. In addition, understanding the interactions between different microbial communities within the CWs will be crucial for developing comprehensive bioremediation strategies. Identifying and characterising the key endophytes and associated metabolites could lead to novel bio-control strategies for pathogen removal in wastewater.
In addition, studies should identify plant–endophyte partnerships with superior pathogen removal capabilities, and this would be highly beneficial for optimising constructed wetland design. Moreover, investigating the ecological impacts of introducing these fungi in constructed wetlands will be essential for assessing their long-term viability and effectiveness.
Author Contributions
R.A.—conceptualisation, investigation, manuscript preparation. W.P. and W.C.—supervision of research, reviewing and editing of manuscript. N.M.—data visualisation and analysis. C.J.Z., E.C., A.I.S. and P.L.—reviewing and editing. M.G. and R.Z.—GC-MS analysis, reviewing and editing. All authors have read and agreed to the published version of the manuscript.
Funding
This research was partially funded by the Bindura University of Science Education, number 202206.
Data Availability Statement
The raw data supporting the conclusions of this article will be made available on request to the corresponding author.
Acknowledgments
Bindura University of Science Education, Biology Laboratory staff.
Conflicts of Interest
The authors declare no conflicts of interest.
References
- Paul, A.; Nag, P. Global trends of population dynamics oncoming 2050. Popul. Geogr. 2024, 46, 1–26. [Google Scholar]
- David, G.; Rana, M.S.; Saxena, S.; Sharma, S.; Pant, D.; Prajapati, S.K. A review on design, operation, and maintenance of constructed wetlands for removal of nutrients and emerging contaminants. Int. J. Environ. Sci. Technol. 2023, 20, 9249–9270. [Google Scholar] [CrossRef]
- Tibebu, S.; Worku, A.; Angassa, K. Removal of Pathogens from Domestic Wastewater Using Small-Scale Gradual Hydroponics Planted with Duranta erecta, Addis Ababa, Ethiopia. J. Environ. Public Health 2022, 2022, 3182996. [Google Scholar] [CrossRef] [PubMed]
- Almuktar, S.A.A.A.N.; Abed, S.N.; Scholz, M. Wetlands for wastewater treatment and subsequent recycling of treated effluent: A review. Environ. Sci. Pollut. Res. 2018, 25, 23595–23623. [Google Scholar] [CrossRef]
- Hussain, I.; Lu, X.; Hussain, J. Nutrients Removal Efficiency Assessment of Constructed Wetland for the Rural Domestic Wastewater Growing Distinct Species of Vegetation. J. Environ. Anal. Toxicol. 2018, 8, 5. [Google Scholar] [CrossRef]
- Stefanakis, A.I.; Akratos, C.S. Removal of pathogenic bacteria in constructed wetlands: Mechanisms and efficiency. In Phytoremediation Management of Environmental Contaminants; Ansari, A.A., Gill, S.S., Gill, R., Eds.; Springer International Publishing: Cham, Switzerland, 2016; pp. 327–346. [Google Scholar]
- Garatsa, C.; Mohammadnezhad, M.; Kostrzynska, E.B.; Nwankwo, B.; Hagan, V.M. Risk Factors of Diarrhoea Among Under-Five Children in Zimbabwe: A Systematic Review. Am. J. Biomed. Sci. Res. 2023, 19, 334–344. [Google Scholar] [CrossRef]
- Badejo, A.A.; Omole, D.O.; Ndambuki, J.M. Municipal wastewater management using Vetiveria zizanioides planted in vertical flow constructed wetland. Appl. Water Sci. 2018, 8, 110. [Google Scholar] [CrossRef]
- Kumar, S.; Pratap, B.; Dubey, D.; Dutta, V. Microbial Communities in Constructed Wetland Microcosms and Their Role in Treatment of Domestic Wastewater. In Emerging Eco-Friendly Green Technologies for Wastewater Treatment, Microorganisms for Sustainability, 18th ed.; Bharagava, R.N., Ed.; Springer: Singapore, 2020; Volume 18, ISBN 978-981-15-1389-3. [Google Scholar]
- Rahman, E.; Izuan, M.; Halmi, B.; Yuso, M.; Samad, A.; Uddin, K.; Mahmud, K.; Yunus, M.; Shukor, A. Design, Operation and Optimization of Constructed Wetland for Removal of Pollutant. Int. J. Environ. Res. Public Health 2020, 17, 8339. [Google Scholar] [CrossRef]
- Alufasi, R.; Parawira, W.; Stefanakis, A.I.; Lebea, P.; Chakauya, E.; Chingwaru, W. Internalisation of Salmonella spp. by Typha latifolia and Cyperus papyrus in vitro and implications for pathogen removal in Constructed Wetlands. Environ. Technol. 2020, 43, 949–961. [Google Scholar] [CrossRef]
- Dhir, B. Effective control of waterborne pathogens by aquatic plants. In Waterborne Pathogens; Prasad, M.V.N., Grobelak, A., Eds.; Elsevier Ltd.: Amsterdam, The Netherlands, 2020; pp. 339–361. [Google Scholar]
- Calheiros, C.S.C.; Ferreira, V.; Magalhães, R.; Teixeira, P.; Castro, P.M.L. Presence of microbial pathogens and genetic diversity of Listeria monocytogenes in a constructed wetland system. Ecol. Eng. 2017, 102, 344–351. [Google Scholar] [CrossRef]
- Mashe, T.; Leekitcharoenphon, P.; Mtapuri-Zinyowera, S.; Kingsley, R.A.; Robertson, V.; Tarupiwa, A.; Kock, M.M.; Makombe, E.P.; Chaibva, B.V.; Manangazira, P.; et al. Salmonella enterica serovar Typhi H58 clone has been endemic in Zimbabwe from 2012 to 2019. J. Antimicrob. Chemother. 2021, 76, 1160–1167. [Google Scholar] [CrossRef]
- Cuneo, C.N.; Sollom, R.; Beyrer, C. The cholera epidemic in Zimbabwe, 2008–2009: A review and critique of the evidence. Health Hum. Rights 2017, 19, 249–264. [Google Scholar]
- Dalu, T.; Barson, M.; Nhiwatiwa, T. Impact of intestinal microorganisms and protozoan parasites on drinking water quality in Harare, Zimbabwe. J. Water Sanit. Hyg. Dev. 2011, 1, 153–163. [Google Scholar] [CrossRef]
- Gufe, C.; Ndlovu, M.N.; Sibanda, Z.; Makuvara, Z.; Marumure, J. Prevalence and antimicrobial profile of potentially pathogenic bacteria isolated from abattoir effluents in Bulawayo, Zimbabwe. Sci. Afr. 2021, 14, e01059. [Google Scholar] [CrossRef]
- Cheung, S.; Zhou, N.A.; Ruhanya, V.; Jesser, K.J.; Nezomba, I.; Musvibe, J.; Manyisa, B.; Nyandoro, G.; Chibukira, P.; Mukaratirwa, A.; et al. Characterisation of enteric pathogens in Harare, Zimbabwe using environmental surveillance and metagenomics. J. Water Health 2025, 23, 477–492. [Google Scholar] [CrossRef] [PubMed]
- Ugboko, H.U.; Nwinyi, O.C.; Oranusi, S.U.; Oyewale, J.O. Childhood diarrhoeal diseases in developing countries. Heliyon 2020, 6, e03690. [Google Scholar] [CrossRef]
- Norman, G.; Pedley, S.; Takkouche, B. Effects of sewerage on diarrhoea and enteric infections: A systematic review and meta-analysis. Lancet Infect. Dis. 2010, 10, 536–544. [Google Scholar] [CrossRef]
- Wu, S.; Lyu, T.; Zhao, Y.; Vymazal, J.; Arias, C.A.; Brix, H. Rethinking intensification of con- structed wetlands as a green eco-technology for wastewater treatment. Environ. Sci. Technol. 2018, 52, 1693–1694. [Google Scholar] [CrossRef]
- Hassan, I.; Chowdhury, S.R.; Prihartato, P.K.; Razzak, S.A. Wastewater Treatment Using Constructed Wetland: Current Trends and Future Potential. Processes 2021, 9, 1917. [Google Scholar] [CrossRef]
- Vymazal, J. Constructed Wetlands for Wastewater Treatment. Water 2010, 2, 530–549. [Google Scholar] [CrossRef]
- Vymazal, J. The Historical Development of Constructed Wetlands for Wastewater Treatment. Land 2022, 11, 174. [Google Scholar] [CrossRef]
- Ramírez-vargas, C.A.; Arias, C.A.; Carvalho, P.; Zhang, L.; Esteve-núñez, A.; Brix, H. Electroactive biofilm-based constructed wetland (EABB-CW): A mesocosm-scale test of an innovative setup for wastewater treatment. Sci. Total Environ. 2019, 659, 796–806. [Google Scholar] [CrossRef]
- Vymazal, J. Constructed wetlands for treatment of industrial wastewaters: A review. Ecol. Eng. 2014, 73, 724–751. [Google Scholar] [CrossRef]
- Kurniawan, S.B.; Ahmad, A.; Said, N.S.M.; Imron, M.F.; Abdullah, S.R.S.; Othman, A.R.; Purwanti, I.F.; Hasan, H.A. Macrophytes as wastewater treatment agents: Nutrient uptake and potential of produced biomass utilization toward circular economy initiatives. Sci. Total Environ. 2021, 790, 148219. [Google Scholar] [CrossRef] [PubMed]
- Bais, H.P.; Weir, T.L.; Perry, L.G.; Gilroy, S.; Vivanco, J.M. The Role of Root Exudates in Rhizosphere Interactions with Plants and Other Organisms. Annu. Rev. Plant Biol. 2006, 57, 233–266. [Google Scholar] [CrossRef]
- Stottmeister, U.; Wießner, A.; Kuschk, P.; Kappelmeyer, U.; Kästner, M.; Bederski, O.; Müller, R.A.; Moormann, H. Effects of Plants and Microorganisms in Constructed Wetlands for wastewater treatment. Biotechnol. Adv. 2003, 22, 93–117. [Google Scholar] [CrossRef] [PubMed]
- Alufasi, R.; Parawira, W.; Zvidzai, C.J.; Stefanakis, A.I.; Musili, N.; Lebea, P.; Chakauya, E.; Chingwaru, W. Performance Evaluation of a Pilot-Scale Constructed Wetland with Typha latifolia for Remediation of Domestic Wastewater in Zimbabwe. Water 2024, 16, 2843. [Google Scholar] [CrossRef]
- Hamad, M.T.M.H. Comparative study on the performance of Typha latifolia and Cyperus Papyrus on the removal of heavy metals and enteric bacteria from wastewater by surface constructed wetlands. Chemosphere 2020, 260, 127551. [Google Scholar] [CrossRef]
- Giácoman-Vallejos, G.; Ponce-Caballero, C.; Champagne, P. Pathogen removal from domestic and swine wastewater by experimental constructed wetlands. Water Sci. Technol. 2015, 71, 1263–1270. [Google Scholar] [CrossRef]
- Kipasika, H.J.; Buza, J.; Smith, W.A.; Njau, K.N. Removal capacity of faecal pathogens from wastewater by four wetland vegetation: Typha latifolia, Cyperus papyrus, Cyperus alternifolius and Phragmites australis. Afr. J. Microbiol. Res. 2016, 10, 654–661. [Google Scholar] [CrossRef]
- Hamad, M.T.M.H. Comparing the performance of Cyperus papyrus and Typha domingensis for the removal of heavy metals, roxithromycin, levofloxacin and pathogenic bacteria from wastewater. Environ. Sci. Eur. 2023, 35, 61. [Google Scholar] [CrossRef]
- Martin, L.; Théophile, F.; Etienne, P.T.; Akoa, A. Removal of faecal bacteria and nutrients from domestic wastewater in a horizontal surface flow wetland vegetated with Echinochloa pyramidalis. Afr. J. Environ. Sci. Technol. 2012, 6, 337–345. [Google Scholar] [CrossRef]
- Kaevska, M.; Lvoncik, S.; Slana, I.; Kulich, P.; Kralik, P. Microscopy, Culture, and Quantitative Real-Time PCR Examination Confirm Internalization of Mycobacteria in Plants. Appl. Environ. Microbiol. 2014, 80, 3888–3894. [Google Scholar] [CrossRef]
- Hirneisen, K.A.; Sharma, M.; Kniel, K.E. Human Enteric Pathogen Internalization by Root Uptake into Food Crops. Foodborne Pathog. Dis. 2012, 9, 396–405. [Google Scholar] [CrossRef] [PubMed]
- Guo, X.; van Iersel, M.W.; Chen, J.; Brackett, R.E.; Beuchat, L.R. Evidence of Association of Salmonellae with Tomato Plants Grown Hydroponically in Inoculated Nutrient Solution. Appl. Environ. Microbiol. 2002, 68, 3639–3643. [Google Scholar] [CrossRef] [PubMed]
- Haichar, Z.; Santaella, C.; Heulin, T.; Achouak, W. Root exudates mediated interactions below ground. Soil Biol. Biochem. 2014, 77, 69–80. [Google Scholar] [CrossRef]
- Jayatilake, P.L.; Munasinghe, H. Antimicrobial Activity of Cultivable Endophytic and Rhizosphere Fungi Associated with “Mile-a-Minute,” Mikania cordata (Asteraceae). BioMed Res. Int. 2020, 2020, 5292571. [Google Scholar] [CrossRef]
- Liang, H.; Xing, Y.; Chen, J.; Zhang, D.; Guo, S.; Wang, C. Antimicrobial activities of endophytic fungi isolated from Ophiopogon japonicus (Liliaceae). BMC Complement. Altern. Med. 2012, 12, 238. [Google Scholar] [CrossRef]
- Aljuraifani, A.; Aldosary, S.; Ababutain, I. In Vitro Antimicrobial Activity of Endophytes, Isolated from Moringa peregrina Growing in Eastern Region of Saudi Arabia. Natl. Acad. Sci. Lett. 2019, 42, 75–80. [Google Scholar] [CrossRef]
- Khan, R.A.A.; Najeeb, S.; Mao, Z.; Ling, J.; Yang, Y.; Li, Y.; Xie, B. Bioactive secondary metabolites from Trichoderma spp. Against phytopathogenic bacteria and root-knot nematode. Microorganisms 2020, 8, 401. [Google Scholar] [CrossRef]
- Sundar, R.D.V.; Arunachalam, S. 2,4-Di-tert-butylphenol from Endophytic Fungi Fusarium oxysporum attenuates the growth of multidrug-resistant pathogens. Front. Microbiol. 2025, 16, 1575021. [Google Scholar] [CrossRef] [PubMed]
- Xing, Y.-M.; Chen, J.; Cui, J.-L.; Chen, X.-M.; Guo, S.-X. Antimicrobial Activity and Biodiversity of Endophytic Fungi in Dendrobium devonianum and Dendrobium thyrsiflorum from Vietman. Curr. Microbiol. 2011, 62, 1218–1224. [Google Scholar] [CrossRef] [PubMed]
- Marcellano, J.P.; Collanto, A.S.; Fuentes, R.G. Antibacterial Activity of Endophytic Fungi Isolated from the Bark of Cinnamomum mercadoi. Pharmacogn. J. 2017, 9, 405–409. [Google Scholar] [CrossRef]
- Beiranvand, M.; Amin, M.; Hashemi-shahraki, A.; Romani, B.; Yaghoubi, S.; Sadeghi, P. Antimicrobial activity of endophytic bacterial populations isolated from medical plants of Iran. Iran. J. Microbiol. 2017, 9, 11–18. [Google Scholar]
- dos Reis, J.B.A.; Lorenzi, A.S.; do Vale, H.M.M. Methods used for the study of endophytic fungi: A review on methodologies and challenges, and associated tips. Arch. Microbiol. 2022, 204, 675. [Google Scholar] [CrossRef]
- Fan, S.; Miao, L.; Li, H.; Lin, A.; Song, F.; Zhang, P. Illumina-based analysis yields new insights into the diversity and composition of endophytic fungi in cultivated Huperzia serrata. PLoS ONE 2020, 15, e0242258. [Google Scholar] [CrossRef]
- Wang, L.; Ren, L.; Li, C.; Gao, C.; Liu, X.; Wang, M.; Luo, Y. Effects of endophytic fungi diversity in different coniferous species on the colonization of Sirex noctilio (Hymenoptera: Siricidae). Sci. Rep. 2019, 9, 5077. [Google Scholar] [CrossRef]
- Hudzicki, J. Kirby-Bauer disk diffusion susceptability test protocol. Am. Soc. Microbiol. 2009, 15, 1–23. [Google Scholar]
- Biemer, J.J. Antimicrobial susceptibility testing by the Kirby-Bauer Disc Diffusion Method. Ann. Clin. Lab. Sci. 1973, 3, 135–140. [Google Scholar]
- Kumari, N.; Menghani, E. Evaluation of antibacterial activity and identification of bioactive metabolites by GCMS technique from rhizospheric Actinomycetes. Indian J. Nat. Prod. Resour. 2020, 11, 287–294. [Google Scholar] [CrossRef]
- Roma, K.; Kiran, S.; Sahoo, D. Extraction and screening of bioactive compounds of some common hydrophytic and wetland plants from East Singbhum, Jharkhand, India. IOSR J. Pharm. 2017, 7, 23–29. [Google Scholar]
- Sharma, D.; Pramanik, A.; Agrawal, P.K. Evaluation of bioactive secondary metabolites from endophytic fungus Pestalotiopsis neglecta BAB-5510 isolated from leaves of Cupressus torulosa D.Don. 3 Biotech 2016, 6, 210. [Google Scholar] [CrossRef]
- Malhadas, C.; Malheiro, R.; Pereira, J.A.; de Pinho, P.G.; Baptista, P. Antimicrobial activity of endophytic fungi from olive tree leaves. World J. Microbiol. Biotechnol. 2017, 33, 46. [Google Scholar] [CrossRef] [PubMed]
- Techaoei, S.; Jirayuthcharoenkul, C.; Jarmkom, K.; Dumrongphuttidecha, T.; Khobjai, W. Chemical evaluation and antibacterial activity of novel bioactive compounds from endophytic fungi in Nelumbo nucifera. Saudi J. Biol. Sci. 2020, 27, 2883–2889. [Google Scholar] [CrossRef] [PubMed]
- Gagan, S.L.; Shivanna, M.B. Diversity and Antibacterial Activity of Endophytic Fungi In Memecylon umbellatum Burm. A Medicinal Plant in the Western Ghats of Karnataka, India. Indian J. Ecol. 2020, 47, 171–180. [Google Scholar]
- dos Santos, I.P.; da Silva, L.C.N.; da Silva, M.V.; de Araújo, J.M.; da Silva Cavalcanti, C.M.; de Menezes Lima, V.L. Antibacterial activity of endophytic fungi from leaves of Indigofera suffruticosa Miller (Fabaceae). Front. Microbiol 2015, 6, 350. [Google Scholar] [CrossRef]
- Begum, I.F.; Mohankumar, R.; Jeevan, M.; Ramani, K. GC MS Analysis of Bio-active Molecules derived from Paracoccus pantotrophus FMR19 and the Antimicrobial Activity Against Bacterial Pathogens and MDROs. Indian J. Microbiol. 2016, 56, 426–432. [Google Scholar] [CrossRef]
- Zhao, F.; Wang, P.; Lucardi, R. Natural Sources and Bioactivities of 2,4-Di-Tert-Butylphenol and Its Analogs. Toxins 2020, 12, 35. [Google Scholar] [CrossRef]
- Seenivasan, A.; Manikkam, R.; Kaari, M.; Sahu, A.K.; Said, M.; Dastager, S.G. 2,4-Di-tert-butylphenol (2,4-DTBP) purified from Streptomyces sp. KCA1 from Phyllanthus niruri: Isolation, characterization, antibacterial and anticancer properties. J. King Saud Univ.-Sci. 2022, 34, 102088. [Google Scholar] [CrossRef]
- Rouvier, F.; Abou, L.; Wafo, E.; Andre, P.; Cheyrol, J.; Khacef, M.; Nappez, C.; Lepidi, H.; Brunel, J.M. Identification of 2,4-Di-tert-Butylphenol as an Antimicrobial Agent Against Cutibacterium acnes Bacteria from Rwandan Propolis. Antibiotics 2024, 13, 1080. [Google Scholar] [CrossRef]
- Mishra, R.; Kushveer, J.S.; Khan, M.I.K.; Pagal, S.; Meena, C.K.; Murali, A.; Dhayalan, A.; Sarma, V.V. 2,4-Di-Tert-Butylphenol Isolated from an Endophytic Fungus, Daldinia eschscholtzii, Reduces Virulence and Quorum Sensing in Pseudomonas aeruginosa. Front. Microbiol. 2020, 11, 1668. [Google Scholar] [CrossRef]
- Putra, M.Y.; Karim, F. Antibacterial and antioxidant activity-guided isolation studies on Fusarium sp. associated with the ascidian Botryllus schlosseri. In Proceedings of the 8th International Conference of the Indonesian Chemical Society (ICICS 2019), Jakarta, Indonesia, 6–13 June 2019. [Google Scholar]
- Singh, V.K.; Mishra, A.; Jha, B. 3-Benzyl-Hexahydro-Pyrrolo[1,2-a]Pyrazine-1,4-Dione Extracted From Exiguobacterium indicum Showed Antibiofilm Activity Against Pseudomonas aeruginosa by Attenuating Quorum Sensing. Front. Microbiol. 2019, 10, 1269. [Google Scholar] [CrossRef]
- Yang, L.; Wang, R.; Lin, W.; Li, B.; Jin, T.; Weng, Q.; Zhang, M. Efficacy of 2,4-Di-tert-butylphenol in Reducing Ralstoniasolanacearum Vilulence: Insights into the Underlying Mechanismisms. ACS Omega 2024, 9, 4647–4655. [Google Scholar] [CrossRef]
Disclaimer/Publisher’s Note: The statements, opinions and data contained in all publications are solely those of the individual author(s) and contributor(s) and not of MDPI and/or the editor(s). MDPI and/or the editor(s) disclaim responsibility for any injury to people or property resulting from any ideas, methods, instructions or products referred to in the content. |
© 2025 by the authors. Licensee MDPI, Basel, Switzerland. This article is an open access article distributed under the terms and conditions of the Creative Commons Attribution (CC BY) license (https://creativecommons.org/licenses/by/4.0/).